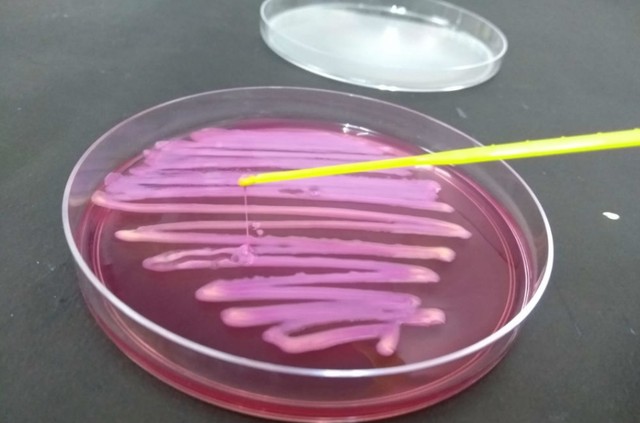
Leia mais sobre o artigo Pesquisa alerta para circulação de superbactérias fora do hospital e uso indiscriminado de antibióticos

Fumaça de queimadas é ameaça à saúde pública, alertam médicos
Queimadas provocaram aumento no número de pessoas buscando socorro médico, diz diretor de hospital em Rondônia. Fumaça de incêndios florestais ataca pulmões e coração. Há quatros dias, Maycon, de 4…